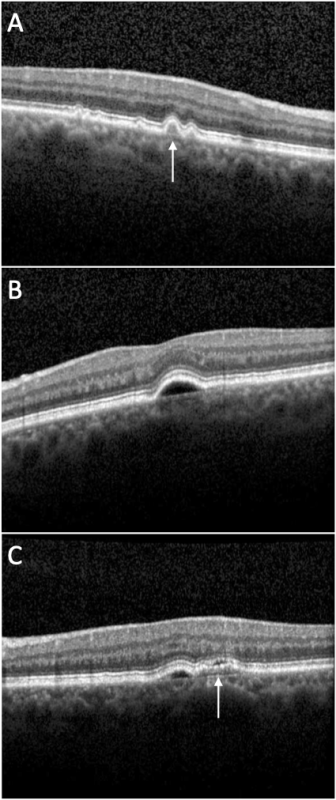

Pigment Epithelial Detachment
All content on Eyewiki is protected by copyright law and the Terms of Service. This content may not be reproduced, copied, or put into any artificial intelligence program, including large language and generative AI models, without permission from the Academy.
Retinal pigment epithelial detachments (PEDs) are structural splitting within the inner aspect of Bruch membrane separating the retinal pigment epithelium (RPE) from the remaining Bruch membrane.
Background
Disease
Retinal pigment epithelial detachments (PEDs) are characterized by separation between the retinal pigment epithelium (RPE) and the innermost aspect of Bruch membrane. The space created by this separation is occupied by blood, serous exudate, drusenoid material, fibrovascular tissue, or a combination of the above.
Etiology
Ocular Diseases
Various ocular and systemic diseases can be associated with PEDs, the most prevalent being age-related macular degeneration (both dry and wet forms). PEDs can also be present in several chorioretinal diseases, including idiopathic central serous chorioretinopathy (CSC), polypoidal choroidal vasculopathy (PCV), and retinal angiomatous proliferation. Rare cases of Vogt-Koyanagi-Harada (VKH) syndrome–associated PEDs have been reported.[2]
Systemic Diseases
PEDs have also been associated with certain systemic conditions, including renal (tubulointerstitial nephritis and uveitis syndrome and type II membranoproliferative glomerulonephritis), inflammatory (systemic lupus erythematosus, inflammatory bowel disease, sarcoidosis), infectious (Blastocystis hominis, poststreptococcal syndrome, neurosyphilis), and neoplastic (paraproteinemias including cryoglobulinemia and IgA or IgM gammopathies) conditions. PEDs have also been associated with Waldenström macroglobulinemia, large cell non-Hodgkin lymphoma (ocular–central nervous system form), choroidal nevi, acute myeloid leukemia, and iatrogenic causes (pamidronate, hemodialysis, organ transplantation).[3] [4]
PEDs in age-related macular degeneration (AMD) can be classified based on their contents. This includes drusenoid PED, serous PED, fibrovascular PED, or mixed component. Drusenoid PEDs are seen mostly in nonneovascular or dry AMD. Serous PEDs are typically associated with the neovascular or wet form of AMD, but their natural history is relatively more favorable. Vascularized PEDs associated with type 1 (sub-RPE) neovascularization and wet AMD, in contrast, have a greater risk of vision loss. Fibrovascular PED is a subset of occult choroidal neovascularization (CNV). In eyes with AMD, it is not uncommon to see more than one type of PED.[3]
The development of CNV has been associated with long-standing PEDs of all forms. Recognition of its existence is a major concern secondary to its increased risk for severe vision loss.[5]
This article largely focuses on PED in the setting of AMD. Features of PED in idiopathic polypoidal choroidal vasculopathy are described in detail here.
Pathophysiology
The retinal pigment epithelium consists of a monolayer of cells, attached to its overlying retinal photoreceptors apically, and the inner collagenous layer of Bruch membrane on its basal surface.[5] Proper anatomical apposition between the retina, the RPE, and Bruch membrane is crucial for proper retinal function, such as retinal metabolism, nutritional support of photoreceptors, phagocytosis of photoreceptor outer segments, and formation of the outer blood-retinal barrier.[5] The inner surface of the RPE cells contains microvilli that interdigitate with the photoreceptor outer segments to stabilize this apposition. Such interdigitations of microvilli do not exist between RPE and Bruch membrane, but these layers are possibly thought to remain attached together through a combination of hydrostatic and osmotic forces from the vitreous as well as possible regions of hemidesmosomes.
PED occurs when the basal lamina of the RPE cell separates from the inner collagenous Bruch membrane. There are several ongoing hypotheses regarding the pathophysiology of PED. Age-related deposition of lipids such as cholesterol esters, triglycerides, and fatty acids in Bruch membrane may thicken and change its permeability, altering retinochoroidal flow. Fluid may accumulate in the sub-RPE space, unable to pass through Bruch membrane, resulting in RPE elevation and a PED. The development of drusen may disrupt fluid outflow through Bruch membrane in a similar fashion.
In rarer inflammatory etiologies of PED, choroidal inflammation might increase vascular permeability and breakdown of the outer blood-retinal barrier leading to protein-rich fluid accumulating under the RPE.[6] Ischemic processes may similarly cause endovascular damage of choroidal and retinal vessels and resulting blood-retinal barrier breakdown.[7]
Diagnosis
Diagnosing PED relies on careful physical examination and further evaluation with various imaging modalities.
History
PEDs are often asymptomatic, but patients can present with painless blurred vision, distortion, metamorphopsia, or induced hyperopia.
Clinical Exam and Diagnostic Imaging
General characteristics: PEDs appear as single or multiple elevated mounds on fundus examination, with sizes ranging from sub-biomicroscopic to several disc diameters. Pigmentary changes such as clumping or mottling may be present. Orange pigment rings and bands on the dome, extending radially over the PED, may indicate chronicity of disease.[8] PEDs are better appreciated in retroillumination during slit-lamp biomicroscopy with a 90D or 78D lens. The development of high-resolution spectral-domain (SD) OCT has allowed more precise and comprehensive assessment and longitudinal follow-up on PEDs.[9]
Drusenoid PED
Examination: Drusenoid PEDs appear as well-circumscribed yellow or yellow-white elevations of the RPE that are usually found within the macula. They may have scalloped borders and a slightly irregular surface. It is not uncommon to observe a speckled or stellate pattern of brown or gray pigmentation on their surface.
OCT: Drusenoid PEDs (Figure 1A, arrow) usually show a smooth contour of the detached hyperreflective RPE band that may demonstrate an undulating appearance. The material beneath the RPE band typically exhibits a dense homogeneous appearance with moderate or high hyperreflectivity. Drusenoid PEDs are typically not associated with overlying subretinal or intraretinal fluid.
Fundus autofluorescence (FAF): Drusenoid PEDs may exhibit decreased FAF, but typically they are isofluorescent or hyperautofluorescent.[3] Drusenoid PEDs often show an evenly distributed, modest increase in the FAF signal surrounded by a well-defined, hypoautofluorescent halo delineating the entire border of the lesion.
Fluorescein angiography (FA): Drusenoid PEDs demonstrate faint hyperfluorescence in the early phase that increases throughout the transit stage of the study without late leakage. This gradual staining without leakage may be sprinkled by hypofluorescent foci corresponding to pigment deposits.
Indocyanine green angiography (ICGA): The content of the drusenoid PED will block the fluorescence emitted from the underlying choroidal vasculature and, therefore, the PED will appear as a homogeneous hypofluorescent lesion during the early phase and remain hypofluorescent throughout the transit.[10]
Serous PED
Examination: Serous PED appears as a distinct circular or oval-like detachment of the RPE. Clear or yellowish orange in color, this dome-shaped elevation of the RPE has a sharply demarcated border. Often PEDs will transilluminate if they are filled predominantly with serous fluid when observed at the slit lamp.
OCT: Serous PEDs (Figure 1B) appear as well-demarcated, abrupt elevations of the RPE with a homogenously hyporeflective sub-RPE space. Enhanced depth imaging (EDI) OCT is useful to determine whether serous PEDs are caused by AMD (normal subfoveal choroidal thickness) or by CSC (increased subfoveal choroidal thickness).[11]
FAF: Serous PEDs most often have an even distribution of hyperautofluorescence corresponding to the detachment and are surrounded by a hypoautofluorescent border.
FA: Serous PEDs demonstrate intense early hyperfluorescence and brisk, progressive pooling within the PED in a homogeneous and well-demarcated manner. Late staining of serous PEDs is typical and may make it difficult to differentiate these PEDs from those that are vascularized based on FA alone. Serous PEDs may obscure the boundaries/extent of an associated CNV. In cases where there is suspicion of associated CNV, ICGA is a useful imaging modality.[3]
ICGA: ICG angiography will typically demonstrate round hypofluorescence with sharply delineated borders; late stages remain typically hypofluorescent as well.
Vascular PED
Examination: Gass reported that a flattened or notched border of the PED is a frequent and important sign of hidden associated CNV.[12] Other biomicroscopic findings suggestive of possible occult CNV association include yellow subretinal and intraretinal exudates that occur typically at the PED margins, subretinal hemorrhages at PED margins, sub-RPE blood which appears darker than subretinal blood with a fluid-level sign, irregular elevation of the PED because of organization in the lesser elevated area, and radial chorioretinal folds surrounding the PED caused by the contraction of Bruch membrane and CNV.[12]
OCT: OCT demonstrates (Figure 1C, arrow) irregular RPE elevation in contrast to the smooth elevation of a serous PED, with heterogenous features often along the back surface of the detached RPE. Scant overlying subretinal fluid may sometimes be seen.
FAF: Fundus autofluorescence imaging of vascularized PEDs has not been evaluated systematically in large series of patients. More work needs to be done to correlate the FAF pattern of PEDs and any associated CNV with findings obtained with FA and OCT.
FA: Stippled or granular hyperfluorescence (not as bright as classic CNV) usually appears within 1-2 minutes. In later frames, these areas can intensify and demonstrate persistent staining or leaking. Other features include tiny focal hyperfluorescent pinpoint spots in mid- to late-phase frames that do not correspond to drusen or foci of depigmentation. An additional FA pattern of vascularized PEDs is a serous PED with a notch (e.g., kidney bean–shaped PED) or hot spot that may be referred to as a vascularized serous PED.
ICGA: Leakage of ICG in the late phases or focal hot spots may be indicative of an underlying associated CNV. A focal bright area of well-defined hyperfluorescence less than 1 disc diameter in size is referred to as a hot spot or focal CNV. Plaque CNV, on the other hand, occupies a large portion of the PED.
Management
Depending on the etiology of the PED, different treatment modalities have been explored to prevent vision loss.
Treatment
Currently, no treatment for serous PED is proven effective, nor are recommendations for treatment guidelines established. Several strategies, however, have been used to treat vascularized PEDs, including laser photocoagulation, photodynamic therapy (PDT), intravitreal steroids, and anti-VEGF therapy. Results from the VIP trial indicated that PDT could significantly reduce the risk of moderate and severe vision loss among patients with subfoveal occult CNV.[13] Another treatment modality, described recently by Costa et al as a pilot trial, is photothrombosis at the neovascular ingrowth site using ICG visualization followed by laser application to feeder vessels. Occlusion of the feeder vessel with cessation of leakage, restoration of macular architecture, and visual improvement were induced in 2 patients with CNV associated with PEDs.[14]
Complications
The natural history of PEDs varies by type, but any PED may be complicated by sight-threatening RPE tears (Figure 2).
The most important FA feature identified that predicted RPE tears was the uneven filling of the PED, with a hypofluorescent central area that remained dark until the late angiographic frames, as well as early hyperfluorescence at the borders of the PED that grew progressively and sometimes demonstrated a notched edge.[15] The RPE tear rate in eyes with PED in natural history studies has been noted to be between 10% and 12%, but this rate seems to be accelerated after anti-VEGF therapy (up to 17%).[3] Other complications include the development of CNV (occult or classic), and geographic atrophy.
Prognosis
Drusenoid PEDs carry the best visual prognosis. Additionally, the location of the PED is important in determining prognosis. Patients with extrafoveal PEDs tend to preserve good visual acuity, whereas patients with subfoveal PEDs can have worse visual outcomes. The course of PEDs also varies by disease etiology. Mudvari et al demonstrated with a mean follow-up of 49 months that 65% of PEDs in CSC completely resolved and the other 35% of PEDs remained persistent.[16] Retinal pigment epithelium atrophy was evident in 86% of patients over the area of the resolved PED. Others have reported similar findings and noted that patients with a persistent PED had poorer visual outcomes.[17]
Some patients with fibrovascular PED can appear relatively asymptomatic and may never experience vision loss despite continued growth of the neovascular lesion.[18] Larger vascularized or hemorrhagic PEDs are typically associated with significant vision loss.
References
- ↑ American Academy of Ophthalmology. Pigment epithelial detachment. https://www.aao.org/image/pigment-epithelial-detachment-2 Accessed July 05, 2019.
- ↑ Khochtali S, Ksiaa I, Megzari K, Khairallah M. Retinal pigment epithelium detachment in acute Vogt-Koyanagi-Harada disease: an unusual finding at presentation. Ocul Immunol Inflamm. 2019;27(4):591-594.
- ↑ 3.0 3.1 3.2 3.3 3.4 Mrejen S, Sarraf D, Mukkamala SK, Freund KB. Multimodal imaging of pigment epithelial detachment: a guide to evaluation. Retina. 2013;33(9):1735-1762.
- ↑ Wolfensberger TJ, Tufail A. Systemic disorders associated with detachment of the neurosensory retina and retinal pigment epithelium. Curr Opin Ophthalmol. 2000;11(6):455-461.
- ↑ 5.0 5.1 5.2 Zayit-Soudry S, Moroz I, Loewenstein A. Retinal pigment epithelial detachment. Surv Ophthalmol. 2007;52(3):227-243.
- ↑ Green K, Paterson CA, Cheeks L, Slagle T, Jay WM, Aziz MZ. Ocular blood flow and vascular permeability in endotoxin-induced inflammation. Ophthalmic Res. 1990;22:287-294.
- ↑ Starita C, Hussain AA, Patmore A, Marshall J. Localization of the site of major resistance to fluid transport in Bruch’s membrane. Invest Ophthalmol Vis Sci. 1997;38:762-767.
- ↑ Yannuzzi LA. Retinal pigment epithelial detachment. In: Yannuzzi LA, ed. Laser Photocoagulation of the Macula. Lippincott; 1989:49-63.
- ↑ Lee SY, Stetson PF, Ruiz-Garcia H, Heussen FM, Sadda SR. Automated characterization of pigment epithelial detachment by optical coherence tomography. Invest Ophthalmol Vis Sci. 2012;53(1):164-170.
- ↑ Arnold JJ, Quaranta M, Soubrane G, Sarks SH, Coscas G. Indocyanine green angiography of drusen. Am J Ophthalmol. 1997;124(3):344-356.
- ↑ Imamura Y, Fujiwara T, Margolis R, Spaide RF. Enhanced depth imaging optical coherence tomography of the choroid in central serous chorioretinopathy. Retina. 2009;29(10):1469-1473.
- ↑ 12.0 12.1 Gass JD. Serous retinal pigment epithelial detachment with a notch. A sign of occult choroidal neovascularization. Retina. 1984;4(4):205-220.
- ↑ Verteporfin in Photodynamic Therapy Study Group. Verteporfin therapy of subfoveal choroidal neovascularization in age-related macular degeneration: two-year results of a randomized clinical trial including lesions with occult with no classic choroidal neovascularization--verteporfin in photodynamic therapy report 2. Am J Ophthalmol. 2001;131(5):541-560.
- ↑ Costa RA, Rocha KM, Calucci D, Cardillo JA, Farah ME. Neovascular ingrowth site photothrombosis in choroidal neovascularization associated with retinal pigment epithelial detachment. Graefes Arch Clin Exp Ophthalmol. 2003;241(3):245-250.
- ↑ Coscas G, Koenig F, Soubrane G. The pretear characteristics of pigment epithelial detachments: a study of 40 eyes. Arch Ophthalmol. 1990;108(12):1687-1693.
- ↑ Mudvari SS, Goff MJ, Fu AD, et al. The natural history of pigment epithelial detachment associated with central serous chorioretinopathy. Retina. 2007;27(9):1168-1173.
- ↑ Loo RH, Scott IU, Flynn HW Jr, et al. Factors associated with reduced visual acuity during long-term follow-up of patients with idiopathic central serous chorioretinopathy. Retina. 2002;22(1):19-24.
- ↑ Blinder KJ, Bradley S, Bressler NM, et al. Effect of lesion size, visual acuity, and lesion composition on visual acuity change with and without verteporfin therapy for choroidal neovascularization secondary to age-related macular degeneration: TAP and VIP report no. 1. Am J Ophthalmol. 2003;136(3):407-418.